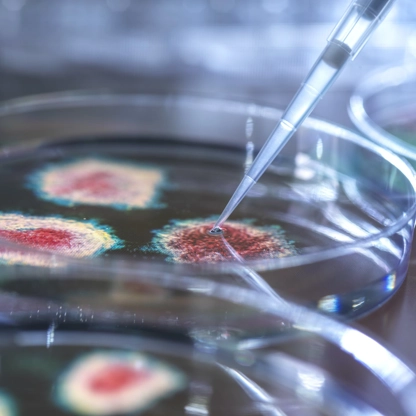

Science Speaks blog

Loading...
About Science Speaks
With regular posts, IDSA’s and HIVMA's blog reminds readers that infectious diseases don’t observe national borders, and effective, evidence-based responses protect us all. With the on-the-ground experience of members, staff and other experts, Science Speaks informs readers about global and domestic impacts of – and answers to – infectious diseases.
The blog also provides updates on IDSA’s and HIVMA’s science-based approaches to improve the health of individuals and their communities and to address challenges facing the field of ID and HIV, both in the U.S. and around the world.
Posts on Science Speaks reflect the authors’ views and not necessarily those of IDSA or HIVMA, nor imply their endorsement.
Share your perspective and experience


Subscribe for blog updates
Sign up to stay current and receive updates about new Science Speaks posts right in your email inbox.